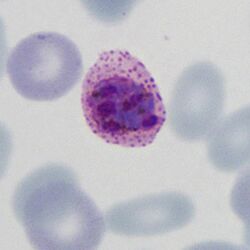

Plasmodium ovale: Morphology: Difference between revisions
From MalariaETC
No edit summary |
No edit summary |
||
| Line 62: | Line 62: | ||
</br><span style="font-size:130%">The schizont</span></br> | </br><span style="font-size:130%">The schizont</span></br> | ||
<gallery mode="nolines" widths=250px heights=250px> | <gallery mode="nolines" widths=250px heights=250px> | ||
File: | File:POSc.jpg|link={{filepath:POSc.jpg}} | ||
File: | File:POS1.jpg|link={{filepath:POS1.jpg}} | ||
</gallery> | </gallery> | ||
<br clear=all> | <br clear=all> | ||
Revision as of 14:40, 13 December 2024
| Navigation |
| >Main malaria Index |
| >Main Species identification page |
Morphology of Plasmodium ovale
(See Malaria Biology pages for an explanation of these stages)
The early trophozoite
The earliest growth stage, this is characterised by fine ring forms with few other changes to red cell or parasite.
- Ring forms are fine and delicate and may be the sole form present (synchronicity)
- Frequently the red cells contain multiple parasites
- Parasites may have a distinctive "double dot" or signet ring form
- Parasites may appear on the accolé forms that appear flattened against the cell membrane
- Affected red cells have normal size and haemoglobin content
The late trophozoite
The later growth stage of trophozoites where parasites modification of the erythrocyte is seen with characteristic added dots and possible minor changes to red cell form:
- Parasites resemble early ring forms, but are thicker and may be slightly larger
- Additional blue/grey dots and clefts are seen in red cell cytoplasm when stained correctly
- These dots have low number a characteristic "dot" or "line" form Maurer's dots and clefts
- Size and shape of infected red cells is usually unaffected, but may become crenated
- The double dot, accolé, and multiple parasite forms remain present
The schizont
The schizont is the asexual form of the malaria parasite that will circulate in blood in most species, but is an uncommon feature in P.falciparum:
- Do not generally circulate in this species consider causes
- The merozoites cluster "untidily" but may be numerous (8-16+ when mature)
- In this species the loose pigment may be seen in clumps between the parasites
- Red cell size is generally unaffected but red cells become pale as haemoglobin is metabolised by the parasites
The gametocyte
The sexual replication in P.falciparum is very distinctive and may be the only form visible (particularly of after treatment).
- male and femaie gametocytes have the appearance of rods although these may be distorted
- The rod shapes may become curved by the red cell membrane to give the characteristic "banana" form”
- The residual membrane (empty of haemoglobin) is often seen as a "blister" to one or both sides of the parasite
- The single chromatin area is in the centre of the parasite, often has pigment overlying it